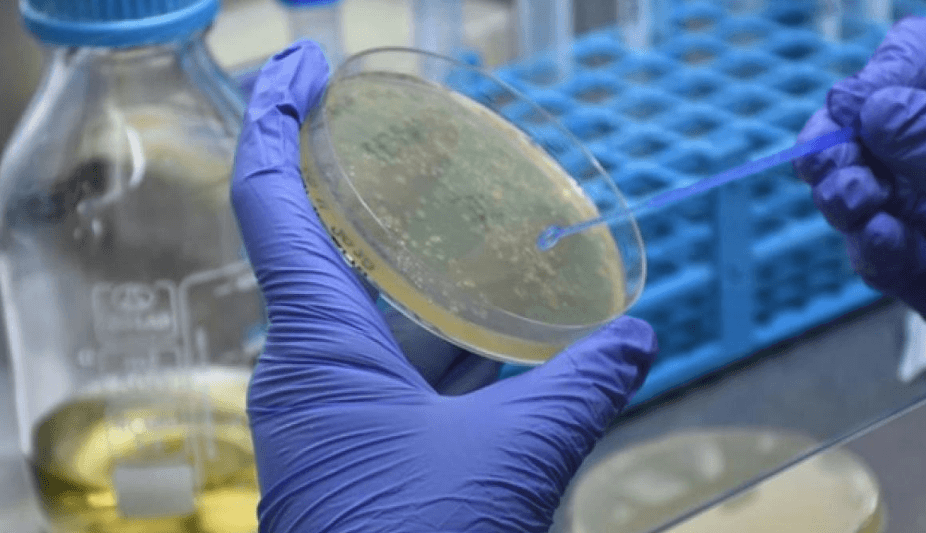
Türkiye'nin ilk mRNA aşısı için geri sayım başladı... 2
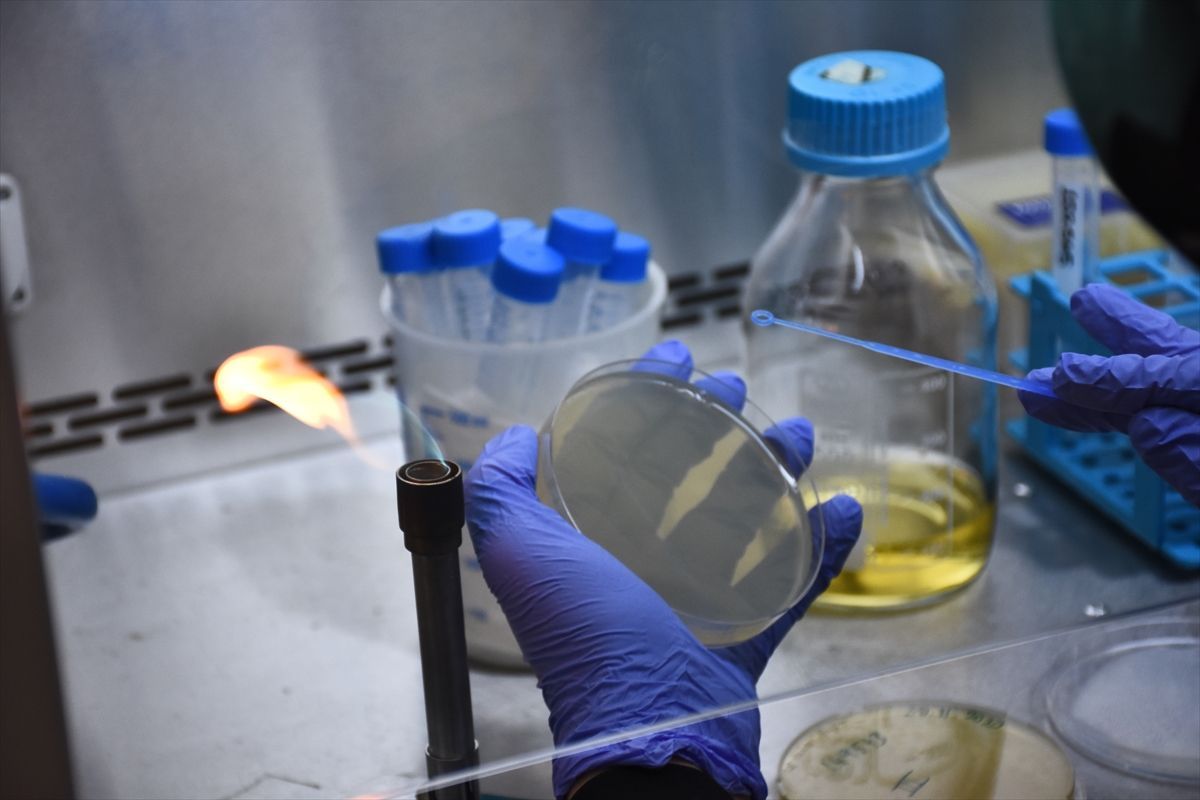
Türkiye'nin ilk mRNA aşısı için geri sayım başladı... 5
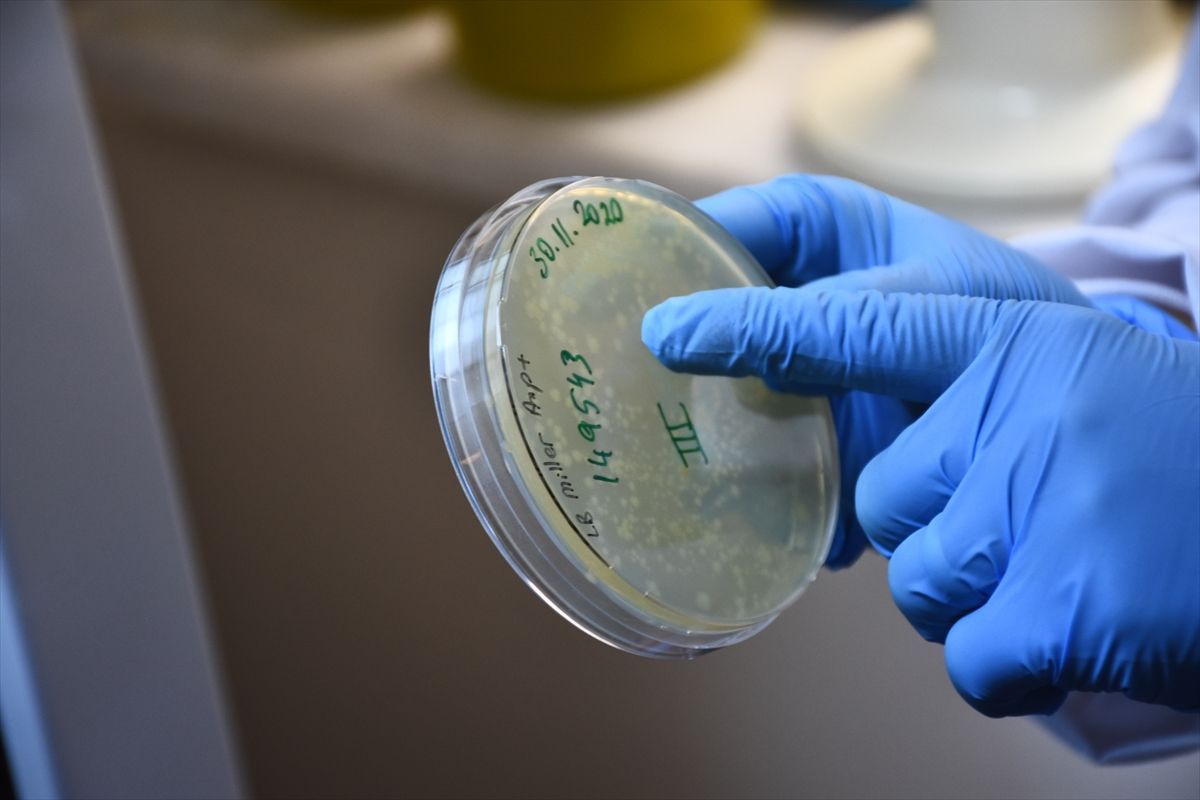
Türkiye'nin ilk mRNA aşısı için geri sayım başladı... 10

Kovid-19’a karşı yerli koronavirüs aşıları için Türk bilim insanlarının çalışmaları aralıksız devam ediyor. TÜBİTAK desteğiyle Türkiye’nin Kovid-19’a karşı ilk mRNA aşı çalışması ise Selçuk Üniversitesi Tıp Fakültesi Tıbbi Genetik Anabilim Dalı bünyesinde devam ediyor.
u003cbu003eYaz bitmeden... :u0026nbsp;u003c/bu003eAşı geliştirme projesinin yürütücüsü Selçuk Üniversitesi Tıp Fakültesi Tıbbi Genetik Anabilim Dalı Öğretim Üyesi Doç. Dr. Nadir Koçak, yerli mRNA aşısında, nisan ayından itibaren ‘Faz’ çalışmalarına geçileceğini belirterek, şunları kaydetti: Yaz bitmeden yerli mRNA aşısının piyasaya çıkması için tüm gücümüzle çalışmaya devam ediyoruz.

u003cbu003eEn geç ocak ayı sonunda ortaya çıkacak : u003c/bu003eTek mRNA aşısı yerine, 3 farklı mRNA aşı dizaynı üzerinde çalışıyoruz. Bu sayede en etkin olan aşı dizaynını tespit ederek, nisan ayından itibaren insan deneyleri, yani faz çalışmalarına başlamayı planlıyoruz. Şuan için mRNA aşılarımızdan ilkinin hayvan deneylerini tamamladık. Diğer ikisinde ise hayvan deneylerine başlamak üzereyiz. Bu deneylerden elde edeceğimiz sonuçlar en geç ocak ayı sonunda ortaya çıkacak.

u003cbu003eTürkiye’de ilk ve tek ekip : u003c/bu003eTürkiye’de Kovid-19’a karşı ilk ve tek mRNA aşısı üzerinde çalışan ekip olduklarının altını çizen Doç. Dr. Koçak açıklamasına şu ifadeleri kullandı: MRNA aşıları dizayn aşıları olduğundan tek çalışma yerine 3 farklı çalışma üzerinden yürümek istedik.
u003cbu003eBioNTech ile bilgi alışverişi :u003c/bu003e 2 yıl önce BioNTech Firması kurucusu Uğur ve Özlem hocalarımızla görüşüp bilgi alışverişinde bulunmuştuk. MRNA aşıları yeni bir teknoloji olduğundan, dünyada sınırlı sayıda çalışma var. Türkiye’deki çalışmaya ilk kez başlayan ekibiz.

Pandemi öncesinde kanser aşıları üzerinde çalışıyorduk. Uğur Şahin Hoca'nın çalışmaları bize yol gösterici oldu. Dünya genelinde mRNA kanser aşısıyla uğraşan grupların Kovid-19 aşısına yönelmesi de bizi tetikledi.

u003cbu003eOda sıcaklığına dayanıklı:u003c/bu003e En büyük hedeflerinin mRNA teknolojisiyle çalışan aşı yönetemini Türkiye’ye kazandırmak olduğunu ifade eden Doç. Dr. Koçak, şöyle devam etti: BioNTech’in aşı sürecini önde tamamlayacağını tahmin ediyorduk. Biz de hazırlıklarımızı buna göre yaptık ve özellikle takip etmeye çalıştık.u0026nbsp;

En büyük amaçlarımızdan biri bu teknolojiyi ülkemize kazandırmaktı. BioNTech ve Moderna’dan yaklaşık 8 ay sonra çalışmaya başladık. Geç başlamak bize, dünya genelinde virüs protein stabilitesine dair verileri anlamımızı sağladı.

MRNA’ya ilişkin tüm yayınları takip ederek, başta BioNTech olmak üzere diğer kuruluşların dizaynlarını görme fırsatımız oldu. Bu sayede daha stabil, daha etkin aşı geliştirme yönünde ilerledik. Geliştirdiğimiz aşıda soğuk zincire gerek kalmayacak. 6 ay kadar oda sıcaklığında dayanabilecek bir molekülle çalışmalarımızı yürütüyoruz.
u003cbu003e4 kez dizaynımızı değiştirdik : u003c/bu003eLaboratuvarda 10 kişilik bir ekibin çalıştığını9 belirten Koçak, şunları söyledi: Yaz aylarında faz çalışmalarını son aşamasını bitirerek Türk mRNA Kovid-19 aşısının piyasaya sunulmasını amaçlıyoruz. Uğur Bey’in yayınlarını sürekli takip ettik.

Pandeminin başlangıcından itibaren virüsün yapısına ilişkin çok sayıda bilimsel makale yayınlandı. İlk başta nasıl dizayn yapacağımızı anlamaya çalıştık ve virüsün protein yapısını anladık. Daha etkin aşı nasıl oluşturulur arayışı nedeniyle 4 kez dizaynımızı değiştirdik.

u003cbu003eDaha az masraflı : u003c/bu003eMRNA aşılarının teknolojik açıdan daha az maliyetle üretilebileceğini ifade eden Doç. Dr. Koçak, açıklamasını şöyle tamamladı: Bu yeni teknoloji aşıların seri üretim maliyetleri, inaktif aşılara göre 10 kat daha düşük masraflı. Tesis kurmak için, onlarca cihaza ihtiyacımız yok. Düşük maliyetle tesis kurabiliyorsunuz. Aslında eş zamanlı olarak bu tesisin oluşması bizi çok mutlu eder.

u0026nbsp;Ülkemizde mRNA teknolojisine sahip aşı üretecek tesisin kurulması gerekiyor. Laboratuvar koşulları ve fiziksel alt yapının oluşturulmasında bilgi anlamında öncülük yapabiliriz. Gerekli yatırım izni çıktıktan 2 ay sonra mRNA aşı üretim tesisi kurulur. Hızlı onay bu işi çözer. Hedefimiz, yaz aylarında bu aşıyı insanlığın hizmetine sunmak” dedi.

u003cbu003eTürkiye’de 16 aşı projesi var :u003c/bu003e Türkiye’de koronavirüs aşısı geliştirmek için 16 aşı projesinde çalışmalar devam ediyor. Kayseri'de Erciyes Üniversitesi'nde (ERÜ) koronavirüse karşı geliştirilen yerli aşıda, Faz-1 çalışmaları geçtiğimiz aralık ayında tamamlanmıştı.




